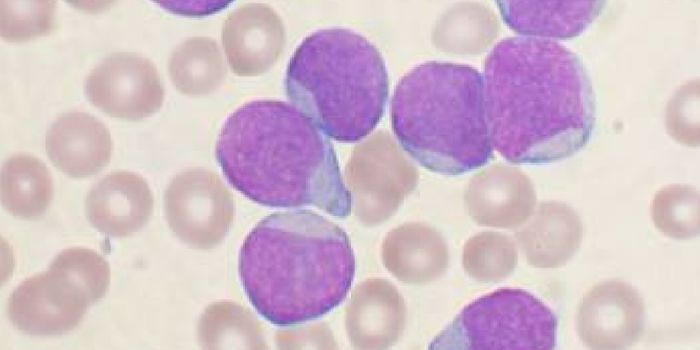
CAR T-Cell Immunotherapy on the Cusp of FDA Approval

Special needs
Clinically, the term special needs is used to describe individuals who require additional assistance due to medical, physical, or psychological disabilities. Special needs can also refer to individuals with delayed functional development.
-
JUL 29, 2017Clinical & Molecular DXNext time you decide to continually push through the pain during your workouts, think twice. A man was recently hospital ...JUL 23, 2017Health & MedicineIn celebration of 4 decades of Assisted Reproductive Technology (ART) here's a roundup of 6 cutting edge technologies in ...Written By: Liat Ben-SeniorJUL 22, 2017Cell & Molecular BiologyMammalian development is a wonder of nature, but there has been debate about how the process is orchestrated. New work s ...Written By: Carmen LeitchJUL 22, 2017CancerA cutting-edge therapy that uses a person’s own immune cells to kill cancer just received a historic vote of confi ...JUL 11, 2017MicrobiologyYogurt is more than an excellent source of protein, calcium, and gut-healthy probiotic bacteria. A protein isolated from ...Written By: Invisiverse PuccioJUL 11, 2017MicrobiologyAh, wine. The bouquet fills your nose. The rich finish fills your mouth with soft flavors of oak and raspberries. The wi ...Written By: Invisiverse PuccioJUL 11, 2017Health & MedicineFighting fire with fire, scientists are harnessing the adaptability of helpful microbes to challenge the adapt ...Written By: Invisiverse PuccioJUL 09, 2017Plants & AnimalsThere are all kinds of corals in our seas, and those that exist at shallower depths are known to sometimes glow because ...Written By: Anthony BouchardJUL 07, 2017Plants & AnimalsPittsburgh Zoo just recently saw the premature birth of a female elephant calf who is now just five weeks old. The calf ...Written By: Anthony BouchardJUL 03, 2017Space & AstronomyJupiter is one of the most mysterious planets in our Solar System, but fortunately, we have a probe with modern observat ...Written By: Anthony BouchardJUL 01, 2017Plants & AnimalsThere's a high probability of vaquita porpoises going extinct very soon, and there's only a small window of oppo ...Written By: Anthony BouchardJUN 30, 2017VideosYou can tell a lot from an animal's teeth. They can tell an animal's age or scientific group classification. They can te ...Written By: Kathryn DeMuth SullivanJUN 24, 2017Cell & Molecular BiologyNew research is challenging a long-held assumption in molecular biology, and it may also help explain some confounding d ...Written By: Carmen LeitchJUN 22, 2017Space & AstronomyIn just a few more weeks, parts of the United States will be gifted with a rare opportunity to experience a total solar ...Written By: Anthony BouchardJUN 21, 2017Space & AstronomySpace junk is a growing problem. The orbital altitudes of Earth are getting so cluttered as we send more stuff into spac ...Written By: Anthony BouchardJUN 19, 2017Health & MedicineImmune cells, like all cells of the human body, come from less-specific ancestor cells, sometimes called progenitor cell ...Written By: Kara MarkerJUN 13, 2017Cell & Molecular BiologyDNA is dynamic inside of cells, and though it can seem to be a tangled thicket, it acts to propel important molecules li ...Written By: Carmen LeitchJUN 12, 2017VideosHumans go through a lot of development in the early years of life, but it may surprise you just how weird some of those ...Written By: Kathryn DeMuth SullivanJUN 02, 2017MicrobiologyBacteria have huge potential as specialized factories that can synthesize precious molecules.Written By: Carmen LeitchJUN 01, 2017Clinical & Molecular DXCould a new device spell the end of painful gynecological exams for women proactive about their cervical cancer screenin ...MAY 31, 2017ImmunologyDrug-resistant bacteria have made curing some infections challenging, if not nearly impossible. By 2050, it's e ...Written By: Invisiverse PuccioMAY 27, 2017Cell & Molecular BiologyResearchers that set out to study metabolism in cancer cells came to an interesting conclusion - some kinds of cancer ha ...Written By: Carmen LeitchMAY 25, 2017NeuroscienceAutism spectrum disorder (ASD) and autism are terms that are used interchangeably to refer to a range of symptoms, disor ...Written By: Brenda Kelley KimMAY 24, 2017Cell & Molecular BiologyResearchers have made a breakthrough in the imaging of living cells that has settled a debate about the cell membrane.Written By: Carmen Leitch
JUL 29, 2017
Clinical & Molecular DX
Next time you decide to continually push through the pain during your workouts, think twice. A man was recently hospital
...
JUL 23, 2017
Health & Medicine
In celebration of 4 decades of Assisted Reproductive Technology (ART) here's a roundup of 6 cutting edge technologies in
...
Written By:
Liat Ben-Senior
JUL 22, 2017
Cell & Molecular Biology
Mammalian development is a wonder of nature, but there has been debate about how the process is orchestrated. New work s
...
Written By:
Carmen Leitch
JUL 22, 2017
Cancer
A cutting-edge therapy that uses a person’s own immune cells to kill cancer just received a historic vote of confi
...
JUL 11, 2017
Microbiology
Yogurt is more than an excellent source of protein, calcium, and gut-healthy probiotic bacteria. A protein isolated from
...
Written By:
Invisiverse Puccio
JUL 11, 2017
Microbiology
Ah, wine. The bouquet fills your nose. The rich finish fills your mouth with soft flavors of oak and raspberries. The wi
...
Written By:
Invisiverse Puccio
JUL 11, 2017
Health & Medicine
Fighting fire with fire, scientists are harnessing the adaptability of helpful microbes to challenge the adapt
...
Written By:
Invisiverse Puccio
JUL 09, 2017
Plants & Animals
There are all kinds of corals in our seas, and those that exist at shallower depths are known to sometimes glow because
...
Written By:
Anthony Bouchard
JUL 07, 2017
Plants & Animals
Pittsburgh Zoo just recently saw the premature birth of a female elephant calf who is now just five weeks old. The calf
...
Written By:
Anthony Bouchard
JUL 03, 2017
Space & Astronomy
Jupiter is one of the most mysterious planets in our Solar System, but fortunately, we have a probe with modern observat
...
Written By:
Anthony Bouchard
JUL 01, 2017
Plants & Animals
There's a high probability of vaquita porpoises going extinct very soon, and there's only a small window of oppo
...
Written By:
Anthony Bouchard
JUN 30, 2017
Videos
You can tell a lot from an animal's teeth. They can tell an animal's age or scientific group classification. They can te
...
Written By:
Kathryn DeMuth Sullivan
JUN 24, 2017
Cell & Molecular Biology
New research is challenging a long-held assumption in molecular biology, and it may also help explain some confounding d
...
Written By:
Carmen Leitch
JUN 22, 2017
Space & Astronomy
In just a few more weeks, parts of the United States will be gifted with a rare opportunity to experience a total solar
...
Written By:
Anthony Bouchard
JUN 21, 2017
Space & Astronomy
Space junk is a growing problem. The orbital altitudes of Earth are getting so cluttered as we send more stuff into spac
...
Written By:
Anthony Bouchard
JUN 19, 2017
Health & Medicine
Immune cells, like all cells of the human body, come from less-specific ancestor cells, sometimes called progenitor cell
...
Written By:
Kara Marker
JUN 13, 2017
Cell & Molecular Biology
DNA is dynamic inside of cells, and though it can seem to be a tangled thicket, it acts to propel important molecules li
...
Written By:
Carmen Leitch
JUN 12, 2017
Videos
Humans go through a lot of development in the early years of life, but it may surprise you just how weird some of those
...
Written By:
Kathryn DeMuth Sullivan
JUN 02, 2017
Microbiology
Bacteria have huge potential as specialized factories that can synthesize precious molecules.
Written By:
Carmen Leitch
JUN 01, 2017
Clinical & Molecular DX
Could a new device spell the end of painful gynecological exams for women proactive about their cervical cancer screenin
...
MAY 31, 2017
Immunology
Drug-resistant bacteria have made curing some infections challenging, if not nearly impossible. By 2050, it's e
...
Written By:
Invisiverse Puccio
MAY 27, 2017
Cell & Molecular Biology
Researchers that set out to study metabolism in cancer cells came to an interesting conclusion - some kinds of cancer ha
...
Written By:
Carmen Leitch
MAY 25, 2017
Neuroscience
Autism spectrum disorder (ASD) and autism are terms that are used interchangeably to refer to a range of symptoms, disor
...
Written By:
Brenda Kelley Kim
MAY 24, 2017
Cell & Molecular Biology
Researchers have made a breakthrough in the imaging of living cells that has settled a debate about the cell membrane.
Written By:
Carmen Leitch